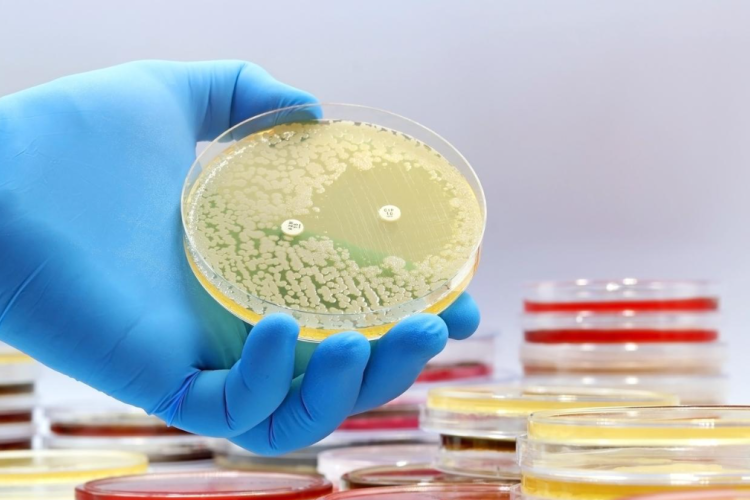
Bacteria 11

Our Clinical Research
The following research studies have been presented at national and international conferences and published online and/or in conference proceedings
Conference: AMR 2025 - Toronto, ON, CANADA November 18 - 19, 2025
A Novel Method for Preserving Antibiotic Effectiveness through Predicting Resistance to Agents Used for Empirical Therapy at Point of Diagnosis of Urinary Tract Infections in Non-Hospitalized Patients

Conference: AMR 2024 - Toronto, ON, CANADA November 19 - 20, 2024
Targeting Antimicrobial Resistance at Point of Diagnosis by a Novel Antibiotic Profiling Method for Guiding Treatment of Urinary Tract Infections and Preventing Urosepsis in Non-Hospitalized Patients

Conference: AMMI Canada/CACMID 2023 - Toronto, ON, CANADA, March 28 - March 31, 2023
Antimicrobial Resistance of Urinary Tract Pathogens Isolated from Non-Hospitalized Pregnant Patients as Determined by the Novel Weighted-Incidence Syndromic Combination Antibiogram (WISCA) Resistance (WISCA-R) Profiling Method

Conference: ASM Microbe 2022 – Washington, DC, USA, June 09-13, 2022
Monitoring Resistance Profiles of Oral Agents Used in the Treatment of Urinary Tract Infections, as Determined by the Novel Weighted-Incidence Syndromic Combination Antibiogram (WISCA) Resistance (WISCA-R) Profiling Method: A Four-Year Study

Virtual Conference: World Microbe Forum 2021 (ASM Microbe-FEMS 2021), June 20-24, 2021
Resistance Profiles of Oral Agents Used in the Treatment of Urinary Tract Infections as Determined by the Novel Weighted-Incidence Syndromic Combination Antibiogram (WISCA) Resistance (WISCA-R) Profiling Method, and Comparison to Previous WISCA-R Findings

Virtual Conference: ASM Microbe 2020 (ASMGM-ICAAC 2020), July 24-28, 2020
Novel Weighted-Incidence Syndromic Combination Antibiogram (WISCA) Resistance (WISCA-R) Profiling of Oral Agents Commonly Used in the Treatment of Community Urinary Tract Infections, and Comparison to Previous WISCA-R Findings

Conference: ASM Microbe 2019 (ASMGM-ICAAC 2019), San Francisco, CA, USA, June 20-24, 2019
Construction of Weighted Incidence Syndromic Combination Antibiogram (WISCA) Resistance Profiles of Oral Agents Tested against Community Urinary Isolates, and Comparison to Physician Empiric Choice

Conference: ASM Microbe 2018 (ASM-ICAAC 2018), Atlanta, GA, USA June 07-11, 2018
Determination of Oral Antimicrobial Agents with the Lowest Resistance Rates among Community Urinary Isolates

Conference: ASM Microbe (ASM-ICAAC), New Orleans, LA, USA, June 01-05, 2017
Antimicrobial Resistance of Urinary Isolates from Non-Hospitalized Pregnant Women

Conference: ASM Microbe (ASM-ICAAC), Boston, MA, USA June 16-20, 2016
Fosfomycin Has the Lowest Resistance Rate among Oral Antimicrobial Agents Tested against Community Uropathogens

Conference: American Society for Microbiology General Meeting, Boston, MA, USA, May 2014
Antimicrobial Resistance of Urinary Gram-Negative Bacilli Recovered from Pregnant Patients

Conference: American Society for Microbiology General Meeting, Denver, CO, USA, May 2013
Tracking Methicillin-Resistant Staphylococcus aureus among Community Clinical Isolates: A Five-Year Study

Conference: American Society for Microbiology General Meeting, San Francisco, CA (USA), June 2012
Increasing Rates of Extended-Spectrum Beta-Lactamase (ESBL) Producing Strains among Community Urinary Isolates and Impact of Patient Age on ESBL Prevalence and Resistance Rates: A Five-Year Study
